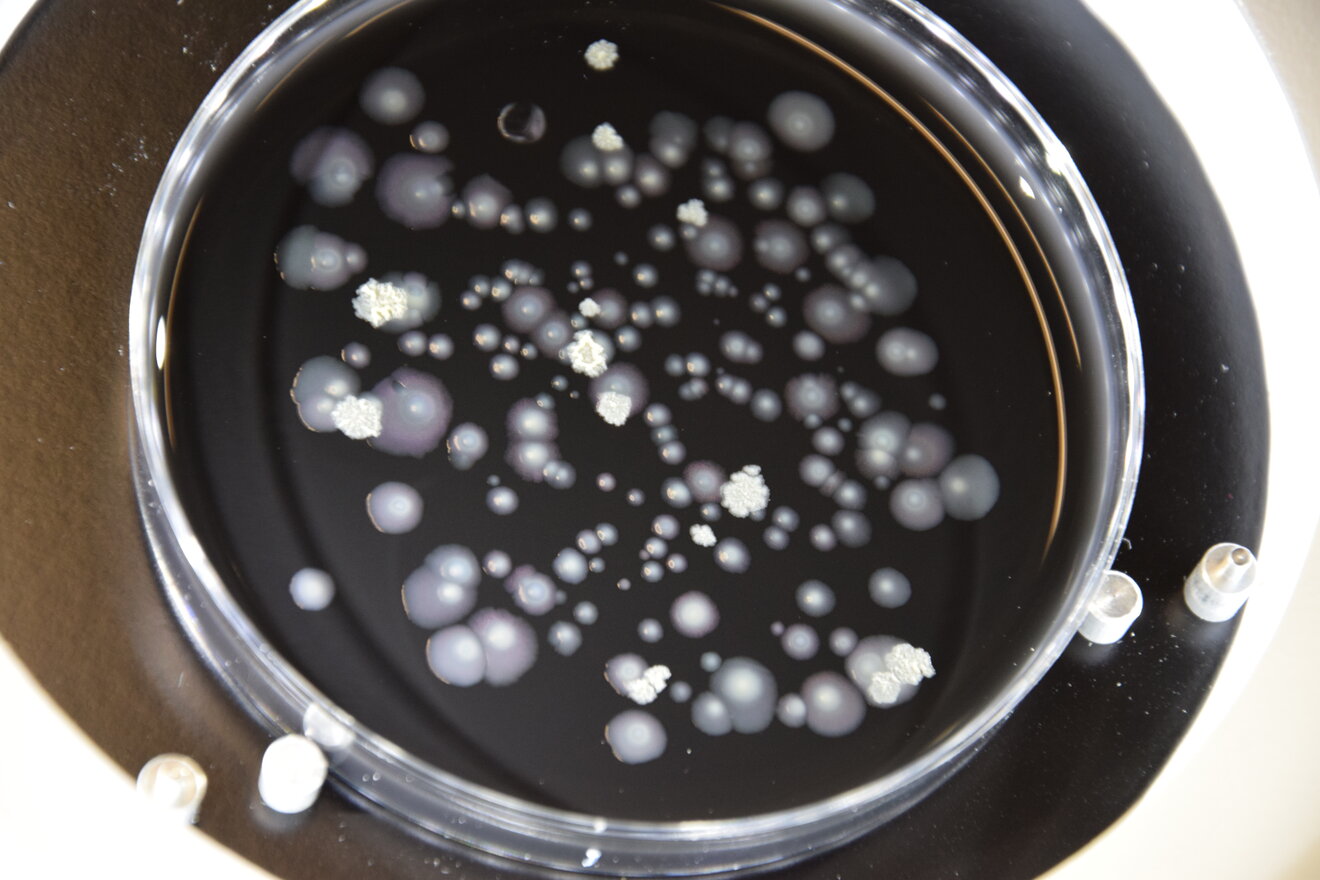

Mikrobiologie
Die Methoden und Verfahren der klassischen kulturellen Mikrobiologie bilden das Fundament der Umweltmikrobiologie im LANUV. Die Kultivierung von Mikroorganismen auf festen Agar-Nährmedien in Petrischalen oder in Flüssigkulturen sind Grundvoraussetzungen, um unterschiedliche Mikroorganismen aus der aquatischen Umwelt nachweisen, isolieren und weitergehend charakterisieren zu können. Die hierfür notwendigen analytischen Werkzeuge werden kontinuierlich auf dem aktuellen Stand gehalten und bei Ausbruchsgeschehen, zur amtlichen Überwachung und für Projektarbeiten eingesetzt.
Im Fokus steht neben der Analytik rund um Legionellen der zusätzliche Ausbau der Fachkompetenz bezüglich anderer hygienerelevanter Mikroorganismen aus der aquatischen Umwelt. Hierbei sind die Mikroorganismen von Interesse, die bereits jetzt ein mögliches Problem in der Umwelt darstellen oder solche, die zu den sogenannten „emerging pathogens“ zählen. Bei den „emerging pathogens“ handelt es sich um neue oder neu auftretende Krankheiten verursachende Mikroorganismen mit zunehmender Ausbreitung, Virulenz oder Resistenz.
In Zusammenarbeit mit Kooperationspartnern wie dem Umweltbundesamt (UBA), dem Nationalen Referenzzentrum für gramnegative Krankenhauserreger (NRZ) oder dem Robert-Koch-Institut (RKI) wird das vorhandene Fachwissen erweitert und ausgetauscht. Die Erkenntnisse fließen unter anderem in DIN-, ISO-, VDI- und UBA-Arbeitskreise ein und unterstützen im Rahmen von NRW-geförderten Forschungsprojekten die Entwicklung und Validierung neuer Analysemethoden.
Unser Ziel: Qualitätsgesicherte, reproduzierbare und vergleichbare Ergebnisse bei der Analyse von herausfordernden komplexen Umweltmatrices in und für NRW.
Unser erarbeitetes Fachwissen wird dauerhaft in Form von Arbeitsblättern und selbst konzipierten Seminaren (siehe NEWS) am Bildungszentrum für die Ver- und Entsorgungswirtschaft (BEW) oder am LANUV-Standort Duisburg an andere Labore, interessierte Kreise und Behörden vermittelt. Unser Ziel ist es, den im LANUV erzielten Wissensmehrwert an Interessierte weiterzugeben.
Die Herstellung von mikrobiologischen Prüfgegenständen und die fachliche Bewertung der Teilnehmerergebnisse der seit 2017 fortlaufend angebotenen mikrobiologischen LANUV-Eignungsprüfungen (Ringversuche) runden das Portfolio der Mikrobiologie im LANUV ab.
Umweltproben können verschiedene anspruchsvolle Herausforderungen an die mikrobiologische Analytik stellen. Neben der Fragestellung zur Homogenität der Proben ist insbesondere der Einfluss interferierender Mikroorganismen (Begleitflora) auf den Nachweis von Legionellen sowie das sichere Differenzieren zwischen Legionellen-verdächtiger und Legionellen-ähnlicher Koloniemorphologie von Bedeutung. Die Untersuchungsmethode der Wahl ist die kulturelle Analytik entsprechend DIN EN ISO 11731:2019-03. Diese Norm ist die Grundlage für reproduzierbare und vergleichbare Ergebnisse. Die speziellen Herausforderungen bei der Untersuchung von Umweltproben stellen dabei einen deutlichen Unterschied zur Trinkwasseranalytik dar.
Zur Harmonisierung der kulturellen Legionellenanalytik in Oberflächen- und Abwasser flossen die langjährigen Erfahrungen des LANUV in das Arbeitsblatt 44 ein. Das Arbeitsblatt dient dem Ziel einer einheitlichen Probenahme, Analytik, Auswertung und Ergebnisangabe. In den Anwendungsbereich der Empfehlung fallen dabei sämtliche Oberflächenwässer und Abwässer bzw. wässrige Proben aus dem Bereich Abwasserableitung und Abwasserbehandlung. Eine Empfehlung für die Probenahme und den Nachweis von Legionellen in Verdunstungskühlanlagen, Kühltürmen und Nassabscheidern stellt das Umweltbundesamt zur Verfügung.
Neben dem Kulturverfahren finden sowohl Immunoseparationsverfahren als auch molekularbiologische Verfahren, wie die quantitative Polymerase-Kettenreaktion (qPCR), Anwendung. Das molekularbiologische qPCR-Verfahren für den Nachweis von Legionella spp. und Legionella pneumophila in komplexen Umweltmatrices ist seit 2019 nach DIN EN ISO 17025 akkreditiert. Mit diesen Methoden können innerhalb eines Tages Aussagen über das Vorkommen von Legionellen in Umweltmatrices erhalten werden.
Da wässrige Umweltproben immer ein gewisses Maß an Heterogenität bezüglich der nachzuweisenden Mikroorganismen aufweisen, stellt die Analytik von wasserbürtigen Bakterien - und dementsprechend auch von antibiotikaresistenten Bakterien - eine Herausforderung dar. Daher ist nicht nur die Auswahl der zu verwendenden kulturellen Methoden, sondern auch eine sachgerechte und valide Homogenisierung der Proben eine wichtige Grundlage zur Erhebung reproduzierbarer und statistisch gesicherter quantitativer Ergebnisse.
Im LANUV werden Oberflächengewässer-, Badegewässer-, Abwasser- und Biofilmproben unter Verwendung von selektiven chromogenen Agar-Nährmedien auf antibiotikaresistente Bakterien untersucht. Im Fokus stehen neben den Vancomycin-Resistenten Enterokokken(VRE) insbesondere Enterobakterien mit bestätigtem Nachweis von Extended Spectrum β-Lactamasen (ESBL) und Carbapenemase-Produzierende Enterobakterien (CPE). Zusätzlich zu der Identifizierung und Charakterisierung dieser Bakterien enthält unser Portfolio den Nachweis Carbapenemase-produzierender Acinetobacter baumannii sowie Pseudomonas aeruginosa.
Neben der sicheren Identifizierung der Bakteriengattung bzw. -art mittels MALDI-TOF MS und/oder stoffwechselphysiologischer Kenndaten erfolgt der Nachweis von Resistenzen und Resistenzmechanismen mit Verfahren zur Bestimmung des Phänotyps und des Genotyps. Seit 2024 stehen uns zusätzlich die Methoden der Typisierung und die Überprüfung von bakteriellen Verwandtschaftsverhältnissen unter Verwendung des Next-Generation Sequencing (NGS) zur Verfügung.
Eine umfangreiche methodische Darstellung kann dem LANUV-Fachbericht 155 "Klinisch-relevante antibiotikaresistente Bakterien in Abwasser und Fließgewässern in NRW" entnommen werden. Zusätzlich stellt das LANUV ein Glossar mit wichtigen Begriffen zum Thema „Antibiotikaresistenzen" zur Verfügung.
Eine sehr schnelle Identifizierungsmethode für Mikroorganismen stellt die MALDI-TOF MS (Matrix Assisted Laser Desorption Ionization-Time Of Flight Mass Spectrometry) dar. Das Verfahren erlaubt eine Identifizierung von Bakterien anhand ihrer Biomoleküle, meist anhand von ribosomalen Proteinen. Durch das Verfahren werden molekulare Fingerabdrücke (Proteinfingerprints) erzeugt und zur Identifizierung mit Referenzspektren abgeglichen.
Das LANUV ist durch den Einsatz des MALDI-TOF-Gerätes in der Lage, Reinkulturen innerhalb weniger Minuten bis auf Art-Ebene zu identifizieren. Eingesetzt wird das MALDI-TOF MS insbesondere bei der Identifizierung von Enterobakterien, Enterokokken, Pseudomonaden, Acinetobacter, Vibrionen, Francisellen und natürlich auch Legionellen. Dies bietet insbesondere in Ausbruchsfällen ein schnelles diagnostisches Hilfsmittel und stellt ein notwendiges Instrument der Spezies-Identifizierung antibiotikaresistenter Bakterien dar.


Externer Inhalt
Schutz Ihrer Daten
An dieser Stelle haben wir den Inhalt eines Drittanbieters, bspw. YouTube, X, Instagram etc., eingebunden. Bitte bestätigen Sie über den Button, dass Sie damit einverstanden sind, diese Inhalte zu sehen!
Ich bin damit einverstanden, dass mir externe Inhalte angezeigt werden. Damit können personenbezogene Daten an Drittplattformen übermittelt werden. Mehr dazu in unserer Datenschutz.